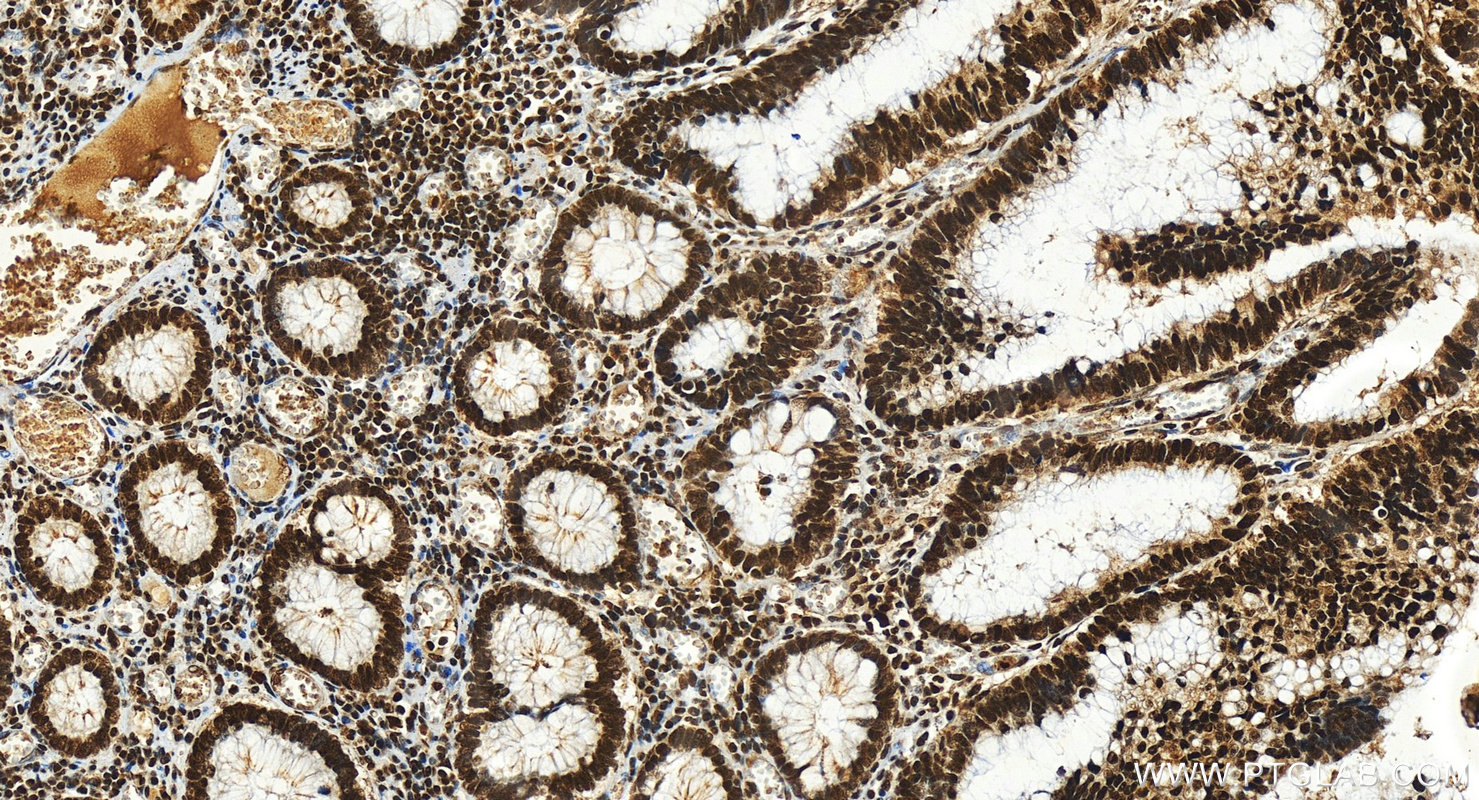
Immunohistochemistry (IHC) staining of human colon cancer tissue using IRF2 Polyclonal antibody (12525-1-AP)

Tested Applications
| Positive WB detected in | HeLa cells, COLO 320 cells, Jurkat cells, mouse colon tissue |
| Positive IP detected in | Jurkat cells |
| Positive IHC detected in | human colon cancer tissue Note: suggested antigen retrieval with TE buffer pH 9.0; (*) Alternatively, antigen retrieval may be performed with citrate buffer pH 6.0 |
| Positive IF/ICC detected in | Jurkat cells |
Recommended dilution
| Application | Dilution |
|---|---|
| Western Blot (WB) | WB : 1:1000-1:4000 |
| Immunoprecipitation (IP) | IP : 0.5-4.0 ug for 1.0-3.0 mg of total protein lysate |
| Immunohistochemistry (IHC) | IHC : 1:500-1:2000 |
| Immunofluorescence (IF)/ICC | IF/ICC : 1:200-1:800 |
| It is recommended that this reagent should be titrated in each testing system to obtain optimal results. | |
| Sample-dependent, Check data in validation data gallery. | |
Published Applications
| KD/KO | See 4 publications below |
| WB | See 9 publications below |
| IHC | See 1 publications below |
| ChIP | See 1 publications below |
Product Information
12525-1-AP targets IRF2 in WB, IHC, IF/ICC, IP, ChIP, ELISA applications and shows reactivity with human, mouse, rat samples.
| Tested Reactivity | human, mouse, rat |
| Cited Reactivity | human, mouse, chicken |
| Host / Isotype | Rabbit / IgG |
| Class | Polyclonal |
| Type | Antibody |
| Immunogen |
CatNo: Ag3220 Product name: Recombinant human IRF2 protein Source: e coli.-derived, PET28a Tag: 6*His Domain: 1-349 aa of BC015803 Sequence: MPVERMRMRPWLEEQINSNTIPGLKWLNKEKKIFQIPWMHAARHGWDVEKDAPLFRNWAIHTGKHQPGVDKPDPKTWKANFRCAMNSLPDIEEVKDKSIKKGNNAFRVYRMLPLSERPSKKGKKPKTEKEDKVKHIKQEPVESSLGLSNGVSDLSPEYAVLTSTIKNEVDSTVNIIVVGQSHLDSNIENQEIVTNPPDICQVVEVTTESDEQPVSMSELYPLQISPVSSYAESETTDSVPSDEESAEGRPHWRKRNIEGKQYLSNMGTRGSYLLPGMASFVTSNKPDLQVTIKEESNPVPYNSSWPPFQDLPLSSSMTPASSSSRPDRETRASVIKKTSDITQARVKSC Predict reactive species |
| Full Name | IRF 2 |
| Calculated Molecular Weight | 349 aa, 39 kDa |
| Observed Molecular Weight | 50 kDa |
| GenBank Accession Number | BC015803 |
| Gene Symbol | IRF2 |
| Gene ID (NCBI) | 3660 |
| RRID | AB_2296127 |
| Conjugate | Unconjugated |
| Form | Liquid |
| Purification Method | Antigen affinity purification |
| UNIPROT ID | P14316 |
| Storage Buffer | PBS with 0.02% sodium azide and 50% glycerol, pH 7.3. |
| Storage Conditions | Store at -20°C. Stable for one year after shipment. Aliquoting is unnecessary for -20oC storage. 20ul sizes contain 0.1% BSA. |
Background Information
IRF2, also known as IFN regulatory factor 2, which belongs to the IRF family. IRF2 specifically binds to the upstream regulatory region of type I IFN and IFN-inducible MHC class I genes (the IFN consensus sequence (ICS)) and represses those genes. IRF2 also acts as an activator for several genes including H4 and IL7. IRF2 constitutively binds to the ISRE promoter to activate IL7. IRF2 is involved in cell cycle regulation through binding the site II (HiNF-M) promoter region of H4 and activating transcription during cell growth. The calculated molecular weight of IRF2 is 39 kDa, but post-modification of IRF2 is about 50 kDa (PMID: 17698501).
Protocols
| Product Specific Protocols | |
|---|---|
| IF protocol for IRF2 antibody 12525-1-AP | Download protocol |
| IHC protocol for IRF2 antibody 12525-1-AP | Download protocol |
| IP protocol for IRF2 antibody 12525-1-AP | Download protocol |
| WB protocol for IRF2 antibody 12525-1-AP | Download protocol |
| Standard Protocols | |
|---|---|
| Click here to view our Standard Protocols |
Publications
| Species | Application | Title |
|---|---|---|
Cancer Lett Lnc-PLCB1 is stabilized by METTL14 induced m6A modification and inhibits Helicobacter pylori mediated gastric cancer by destabilizing DDX21 | ||
Int J Mol Sci Analysis of miRNA Expression Profiling of RIP2 Knockdown in Chicken HD11 Cells When Infected with Avian Pathogenic E. coli (APEC). | ||
Virol J IRF2 inhibits ZIKV replication by promoting FAM111A expression to enhance the host restriction effect of RFC3.
| ||
J Immunol Res Propofol Ameliorates Microglia Activation by Targeting MicroRNA-221/222-IRF2 Axis.
| ||
Transl Oncol IRF2-ferroptosis related gene is associated with prognosis and EMT in gliomas
|